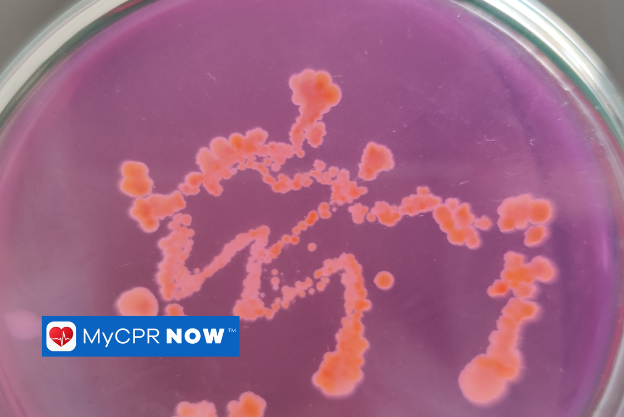

How Are Bloodborne Pathogens Transmitted? Essential Insights
Share
Understanding Bloodborne Pathogens and Their Risks
Bloodborne pathogens are infectious microorganisms that can be transmitted through contact with contaminated blood or other bodily fluids. These pathogens pose serious health risks and are responsible for infections that can lead to long-term complications or even life-threatening conditions. Understanding how they spread and taking preventive measures is crucial for maintaining a safe environment in healthcare, workplace settings, and daily interactions.
Common Bloodborne Pathogens
Several pathogens can be transmitted through blood exposure, but the most concerning include:
-
Hepatitis B virus (HBV) – A virus that affects the liver, potentially leading to chronic disease or liver failure.
-
Hepatitis C (HCV) – Another liver-infecting virus, often causing long-term complications without noticeable symptoms in early stages.
-
Human Immunodeficiency Virus (HIV) – A virus that attacks the immune system, leading to acquired immunodeficiency syndrome (AIDS) if untreated.
Methods of Bloodborne Pathogen Transmission
Bloodborne pathogens are primarily spread through direct contact with infected blood or body fluid. Certain situations pose a higher risk of exposure, making it essential to follow strict safety protocols.
Direct Blood Contact
The most common method of transmission occurs when infected blood enters another person’s bloodstream through cuts, open wounds, or mucous membranes. Even minor skin abrasions, broken skin, or cracked skin can serve as entry points for these pathogens.
Needlestick Injuries
Healthcare workers, laboratory technicians, and first responders are at high risk of exposure due to accidental needlestick injuries. Broken glass is another type of contaminated sharp that should be handled with care to prevent injury and potential contamination. Improper handling of needles, syringes, or other sharp medical instruments can lead to direct blood exposure.
Mucous Membrane Exposure
Bloodborne pathogens can enter the body through the mucous membranes of the eyes, nose, or mouth. This can happen when contaminated blood splashes onto these sensitive areas, which is why protective barriers like face shields and goggles are necessary in high-risk environments.
Unprotected Sexual Contact
Unprotected sex is another common mode of transmission for bloodborne viruses such as HIV and hepatitis. The virus can spread through contact with infected semen, vaginal secretions, or blood during sexual activity.
Contaminated Instruments and Surfaces
Bloodborne pathogens can survive outside the body for varying lengths of time, depending on the environment. Surfaces that are visibly contaminated with blood should be handled with extreme care to prevent the spread of infection. Contaminated medical instruments, razors, or improperly sanitized tattoo and piercing equipment can spread infection if not properly cleaned and disinfected.
Sharing Needles or Drug Equipment
Individuals who share needles, syringes, or drug preparation equipment have a significantly higher risk of contracting bloodborne infections. The reuse of contaminated needles allows pathogens to transfer directly into the bloodstream.
Mother-to-Child Transmission
Pregnant individuals with a bloodborne infection can pass it to their baby during childbirth through various body fluids, including amniotic fluid, or, in some cases, through breastfeeding. Proper medical intervention can reduce the risk of transmission and improve outcomes for both mother and child.
Who is at Risk?
While healthcare professionals face the highest risk of exposure, other individuals may also encounter bloodborne pathogens in certain situations. Occupational exposure to bloodborne pathogens necessitates the implementation of safety protocols to minimize risks. Those most at risk include:
-
Healthcare and emergency medical workers
-
Law enforcement personnel and first responders
-
Laboratory technicians and researchers
-
Tattoo and piercing artists
-
Individuals engaging in high-risk sexual behaviors
-
Those who share needles or drug paraphernalia
Preventing Bloodborne Pathogen Transmission
Taking preventive steps can greatly reduce the risk of exposure to bloodborne pathogens. The most effective ways to prevent transmission include:
-
Using Personal Protective Equipment (PPE) – Gloves, masks, goggles, and face shields provide a barrier against direct blood contact.
-
Proper Hand Hygiene – Washing hands thoroughly with soap and water reduces the risk of contamination.
-
Safe Handling of Needles and Sharps – Using puncture-resistant sharps containers and never recapping used needles help prevent injuries.
-
Disinfecting Surfaces and Equipment – Cleaning and properly sterilizing medical tools and work areas reduce contamination risks.
-
Following Universal Precautions – Treating all blood and bodily fluids as potentially infectious ensures consistent safety practices.
-
Vaccination – Receiving the hepatitis B vaccine offers protection against one of the most common bloodborne pathogens.
Conclusion
Bloodborne pathogens present serious health risks, but understanding how they are transmitted and taking the proper precautions can help prevent infections. Whether in healthcare settings, workplaces, or personal interactions, following safety guidelines and practicing good hygiene are essential in minimizing exposure. Being informed and proactive is the best way to protect both individuals and communities from the dangers of bloodborne pathogens.
FAQs
What are bloodborne pathogens?
Bloodborne pathogens are infectious microorganisms found in human blood and bodily fluids that can cause serious diseases, such as hepatitis B, hepatitis C, and HIV.
Can bloodborne pathogens be transmitted through casual contact?
No, bloodborne pathogens do not spread through casual contact such as hugging, shaking hands, or sharing food. They require direct blood-to-blood contact or exposure to bodily fluids.
How long can bloodborne pathogens survive outside the body?
The survival time depends on the pathogen. Hepatitis B can live on surfaces for several days, while HIV becomes inactive within hours once outside the body.
What should you do if you are exposed to potentially infected blood?
Immediately wash the affected area with soap and water, seek medical attention, and follow post-exposure protocols, including potential testing and treatment.
Can wearing gloves completely prevent bloodborne pathogen transmission?
Gloves provide a protective barrier but do not guarantee full protection. Proper disposal, handwashing, and additional protective measures are necessary for complete safety.

